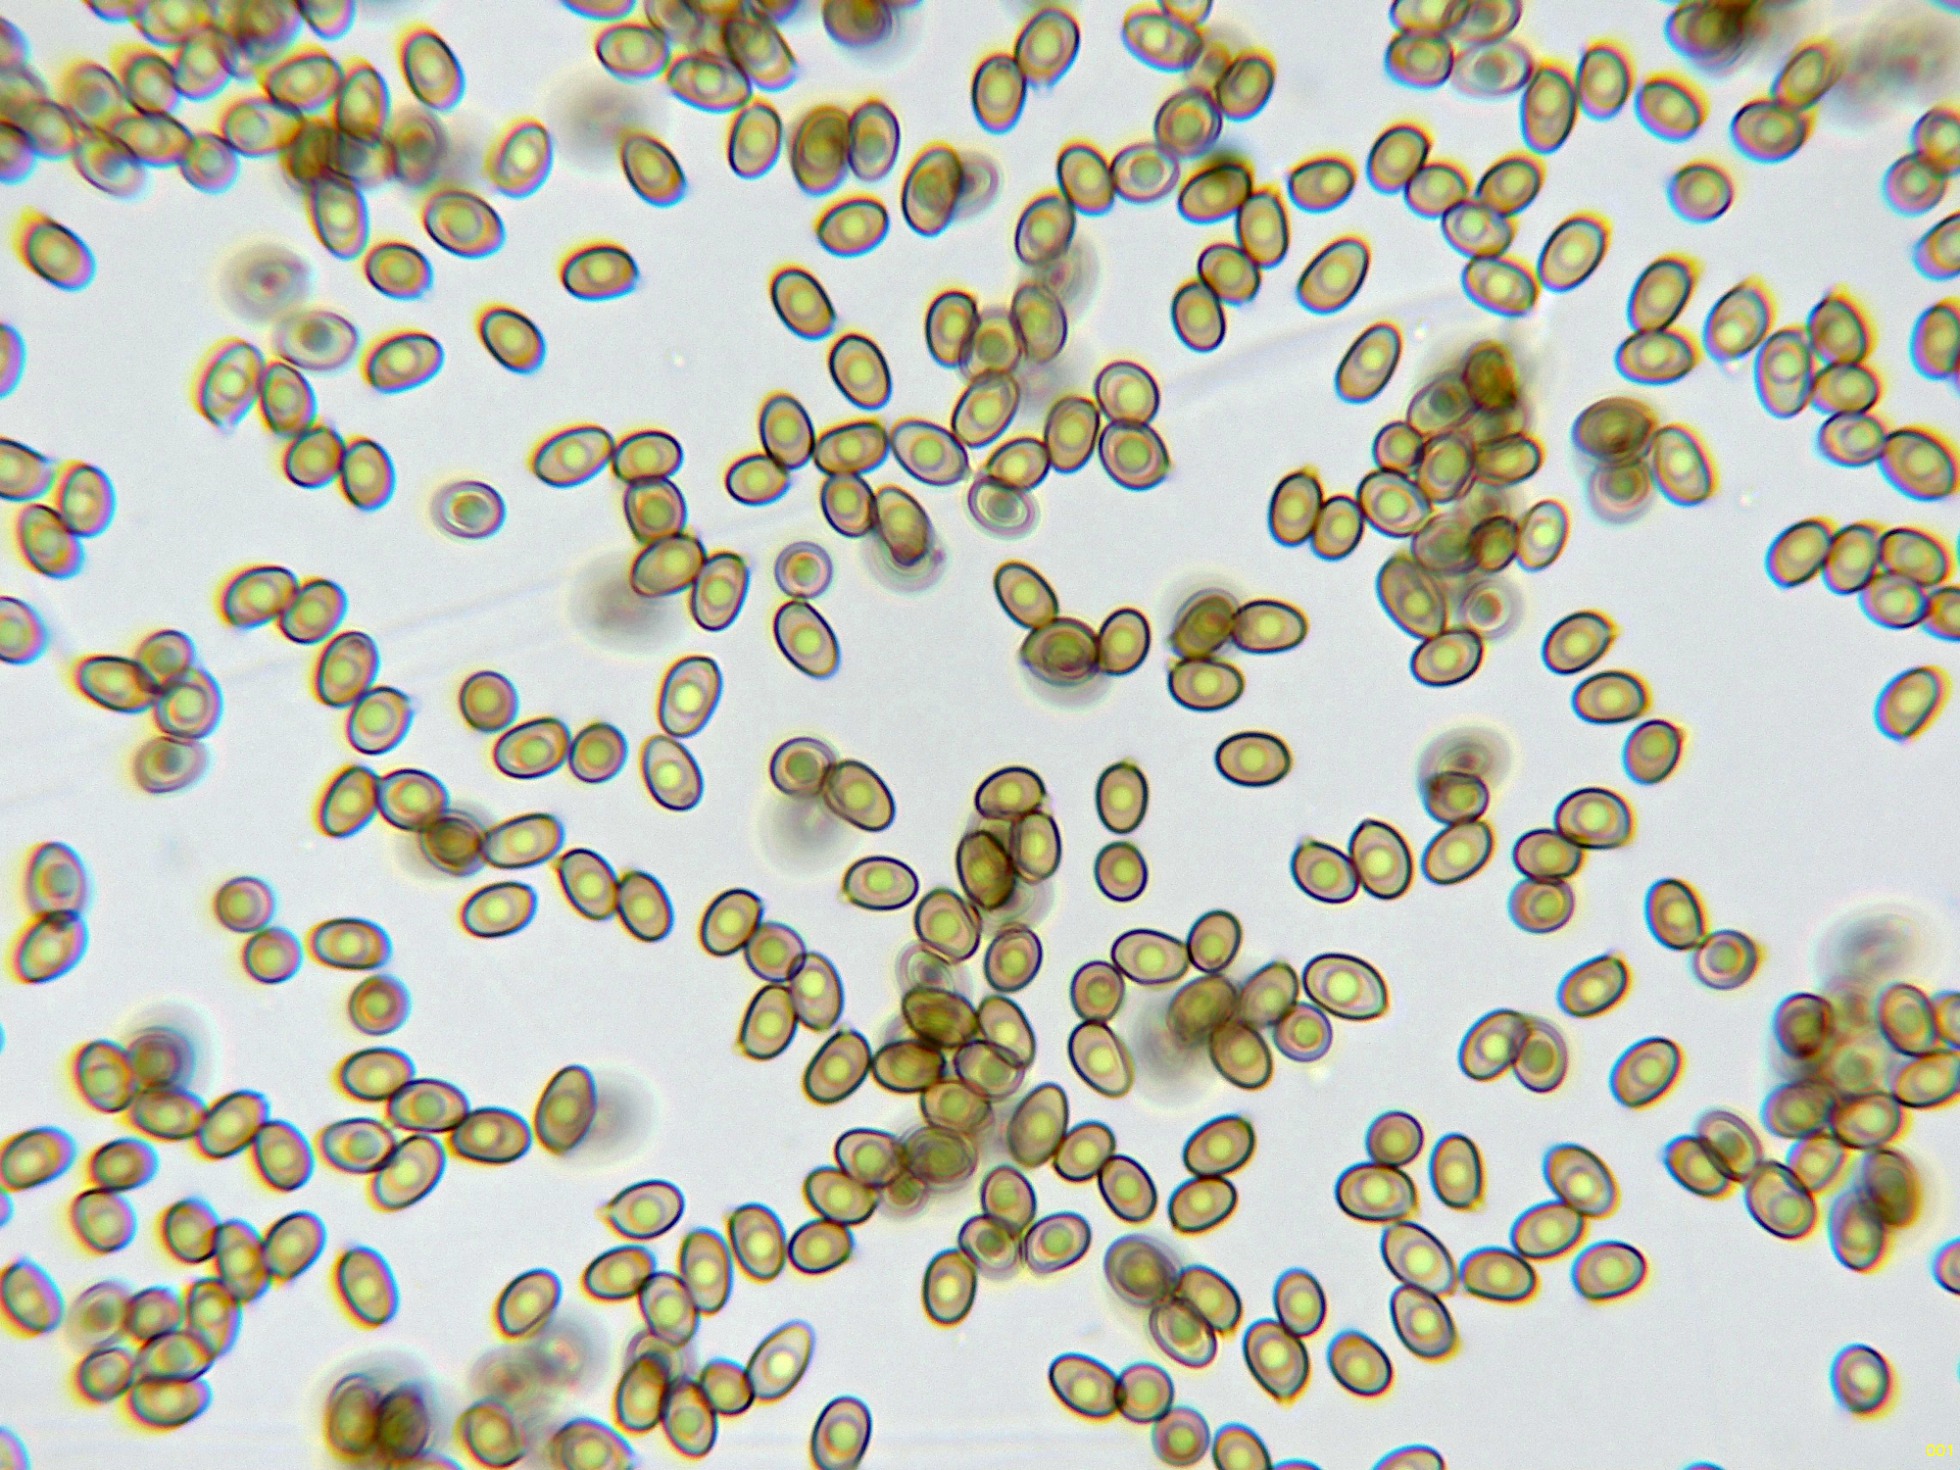
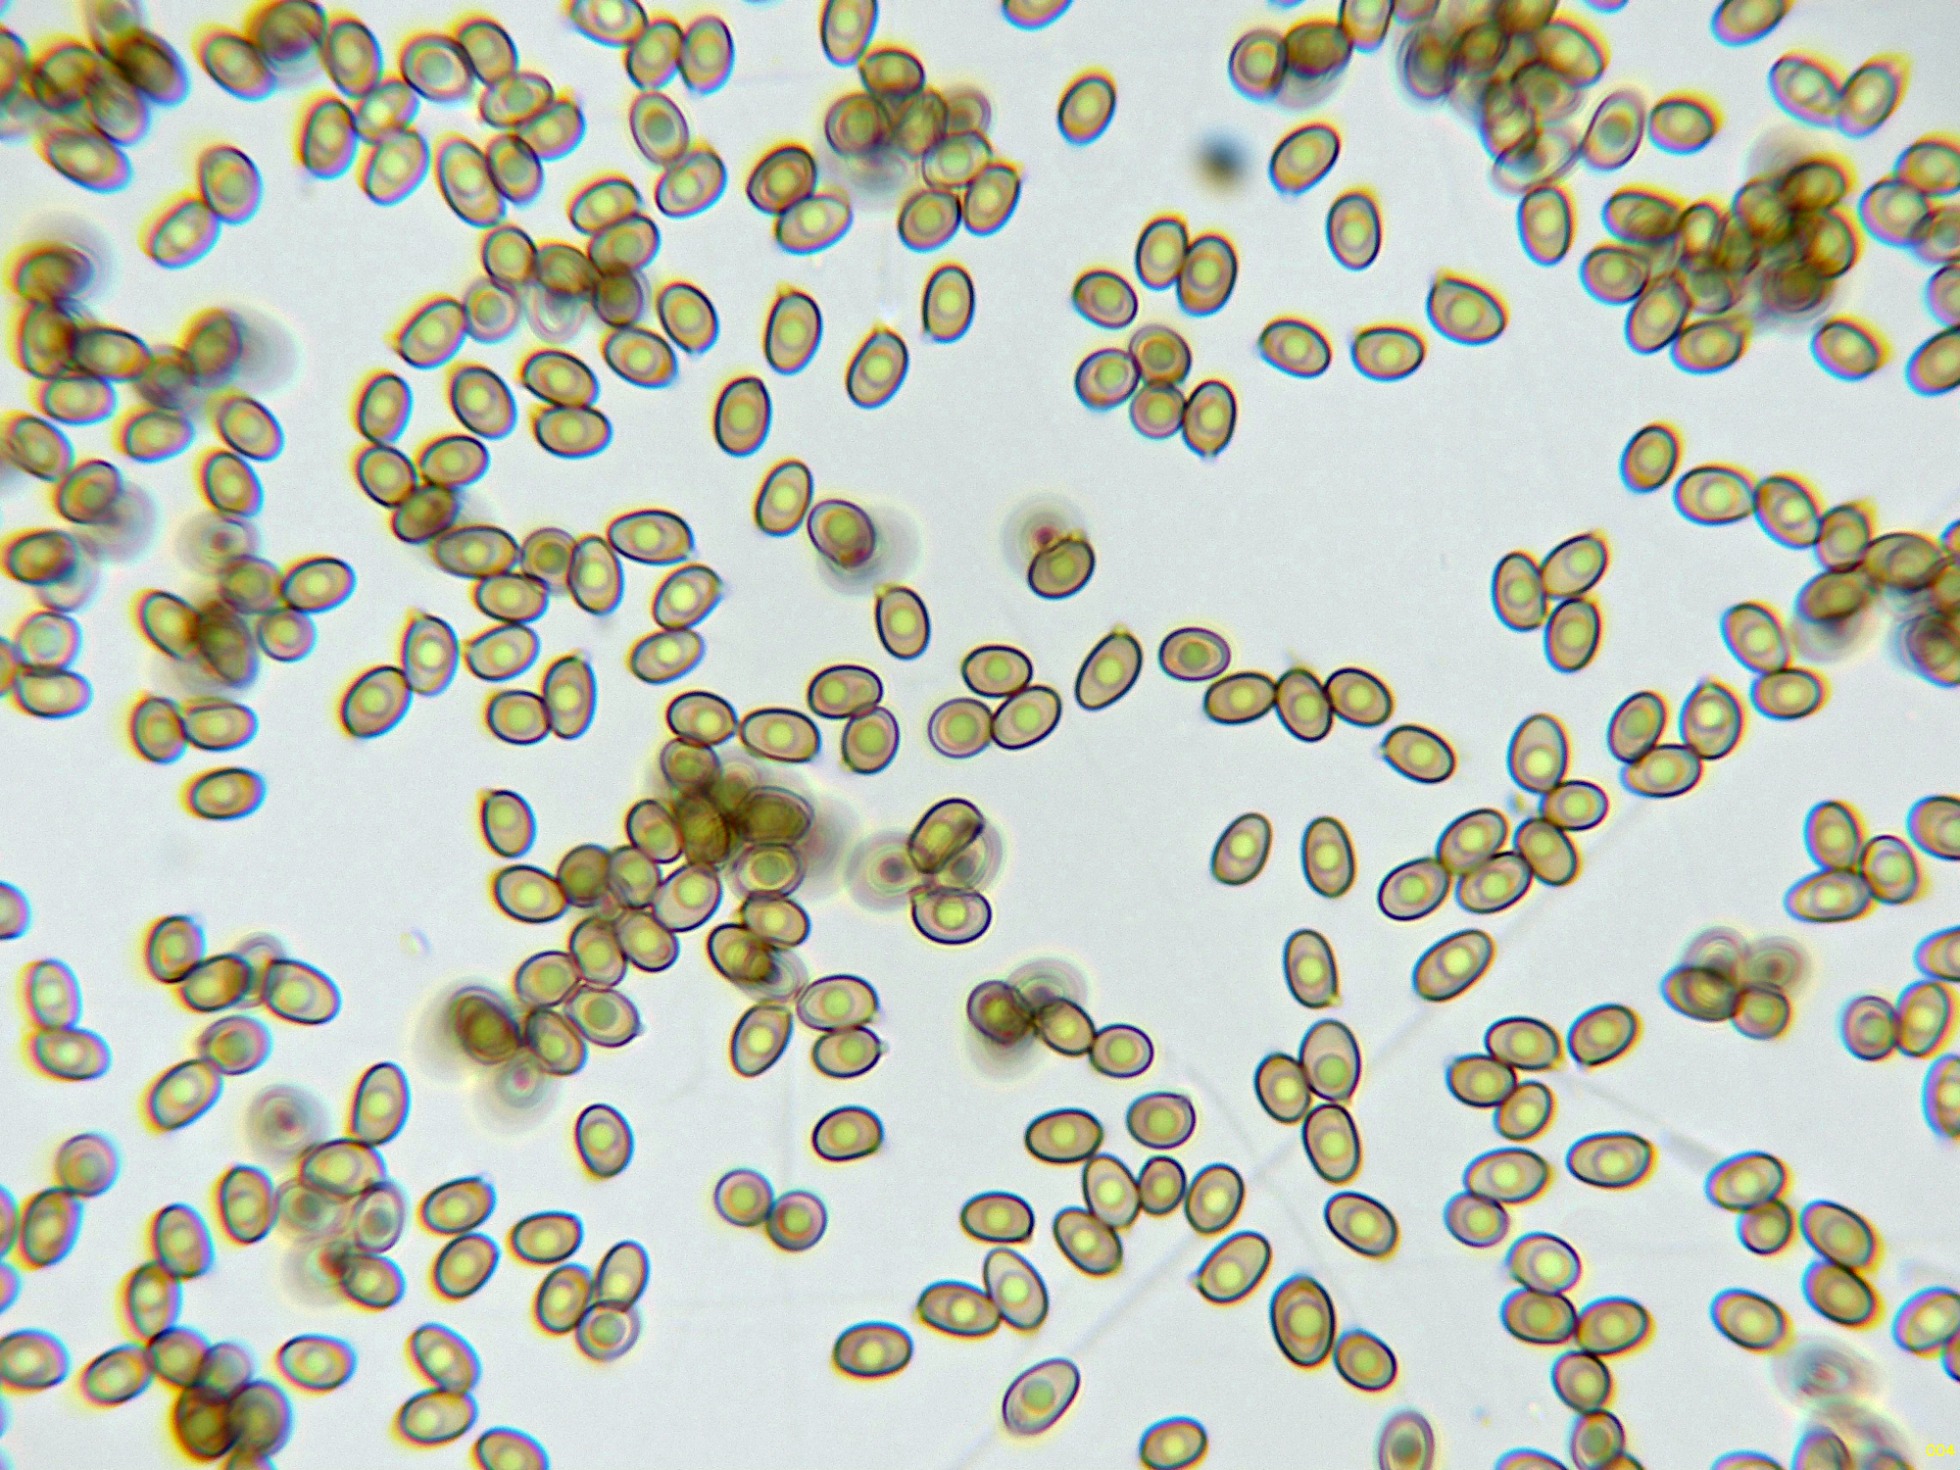

- Foro
- Foros sobre Micología de fungipedia
- Microscopía
- Una docena del pasado 1 de diciembre. Microscopía.
 Una docena del pasado 1 de diciembre. Microscopía.
Una docena del pasado 1 de diciembre. Microscopía.
- Josep Torres
-
 Autor del tema
Autor del tema
- Ausente
- Moderador
-

Menos
Más
- Mensajes: 8746
- Gracias recibidas: 8379
1 año 3 meses antes - 1 año 3 meses antes #110389
por Josep Torres
Hola.
Un resto de lo que dio de si la recogida de muestras del pasado 1 de diciembre.
Un Corticial que solo me había encontrado en una ocasión allá por noviembre de 2021, con basidios tabicados transversalmente el Achroomyces effusus.
Las hifas subhimeniales con fíbulas:
Los basidios tabicados en solución de Rojo Congo diluido:
Los basidios en reactivo de Melzer:
Las esporas en reactivo de Melzer, inamiloides:
Y las esporas en agua:
Estas esporas obtenidas por esporulación natural y en agua con unas medidas de:
(6) 6.3 - 7.6 (8.1) × (3.5) 3.7 - 4.6 (5) µm
Q = (1.5) 1.54 - 1.9 (2) ; N = 40
Me = 7 × 4.2 µm ; Qe = 1.7
Un Agarius que por su enrojecimiento prácticamente al instante llegué a pensar en Agaricus langei, tocará seguir buscando, ya que se trata del abundante Agaricus sylvaticus:
Las hifas de la suprapellis en agua:
Arista laminar en Rojo Congo:
Los basidios de la cara laminar:
Las esporas en agua:
Estas esporas obtenidas por esporulación natural y en agua con unas medidas de:
(4.8) 5 - 5.7 (6.1) × (3.1) 3.3 - 3.8 (4) µm
Q = (1.2) 1.3 - 1.6 (1.7) ; N = 20
Me = 5.3 × 3.6 µm ; Qe = 1.5
Un ascomiceto que siempre me lo he encontrado en hayedo, con un apellido que hace referencia a su aspecto, la Bertia moriformis:
Los ascomas a 20 aumentos:
Los ascomas a 40 aumentos:
Sección de los ascomas con la masa gelatinosa donde se alojan los ascos:
Ascos en reactivo de Melzer a 400 aumentos:
Ascos en agua a 1000 aumentos:
Esporas en agua a 400 aumentos:
Esporas en agua a 1000 aumentos:
Estas esporas con unas medidas de:
(46.8) 47.7 - 57.4 (59.8) × (6.5) 6.9 - 8.5 (9.4) µm
Q = (5) 6 - 8.3 (9.1) ; N = 20
Me = 53.7 × 7.6 µm ; Qe = 7.1
Un Crepidotus ya un poco pasadete, con esporas esféricas y minuciosamente verrucosas, el Crepidotus cesatii.
Las hifas de la suprapellis:
Los queilocistidios:
Los basidios:
Y las esporas libres:
Un muy diminuto basidiomiceto blanco sobre una hoja de haya, la Flagelloscypha minutisima:
Los basidiomas a 40 aumentos:
Un apilado de imágenes a 100 aumentos:
Los pelos externos y en la base de estos los basidios:
En este estudio no pude conseguir esporas.
Un Polyporal que oscurece sensiblemente a tonos marrones con el roce o la manipulación, un Ischnoderma, si debo ser honesto no encuentro diferencias entre este y el Ischnoderma benzoinum, si lo he separado del anterior ha sido solo por el sustrato, sobre un tronco de haya el Ischnoderma resinosum, al Ischnoderma benzoinum Ryvarden lo sitúa solo sobre coníferas, y al Ischnoderma resinosum sobre Fagus, aunque el mismo Ryvarden admite no encontrar diferencias entre ambos:
Superficie poroide a 20 aumentos:
Las hifas subiculares:
Las hifas subiculares en reactivo de Melzer:
Los basidios:
Unos basidios en reactivo de Melzer, tetraspóricos:
Muy pocas esporas conseguidas, añado una imagen de una espora ampliada con sus medidas:
Seguimos.........................................................
Un resto de lo que dio de si la recogida de muestras del pasado 1 de diciembre.
Un Corticial que solo me había encontrado en una ocasión allá por noviembre de 2021, con basidios tabicados transversalmente el Achroomyces effusus.
Las hifas subhimeniales con fíbulas:
Los basidios tabicados en solución de Rojo Congo diluido:
Los basidios en reactivo de Melzer:
Las esporas en reactivo de Melzer, inamiloides:
Y las esporas en agua:
Estas esporas obtenidas por esporulación natural y en agua con unas medidas de:
(6) 6.3 - 7.6 (8.1) × (3.5) 3.7 - 4.6 (5) µm
Q = (1.5) 1.54 - 1.9 (2) ; N = 40
Me = 7 × 4.2 µm ; Qe = 1.7
Un Agarius que por su enrojecimiento prácticamente al instante llegué a pensar en Agaricus langei, tocará seguir buscando, ya que se trata del abundante Agaricus sylvaticus:
Las hifas de la suprapellis en agua:
Arista laminar en Rojo Congo:
Los basidios de la cara laminar:
Las esporas en agua:
Estas esporas obtenidas por esporulación natural y en agua con unas medidas de:
(4.8) 5 - 5.7 (6.1) × (3.1) 3.3 - 3.8 (4) µm
Q = (1.2) 1.3 - 1.6 (1.7) ; N = 20
Me = 5.3 × 3.6 µm ; Qe = 1.5
Un ascomiceto que siempre me lo he encontrado en hayedo, con un apellido que hace referencia a su aspecto, la Bertia moriformis:
Los ascomas a 20 aumentos:
Los ascomas a 40 aumentos:
Sección de los ascomas con la masa gelatinosa donde se alojan los ascos:
Ascos en reactivo de Melzer a 400 aumentos:
Ascos en agua a 1000 aumentos:
Esporas en agua a 400 aumentos:
Esporas en agua a 1000 aumentos:
Estas esporas con unas medidas de:
(46.8) 47.7 - 57.4 (59.8) × (6.5) 6.9 - 8.5 (9.4) µm
Q = (5) 6 - 8.3 (9.1) ; N = 20
Me = 53.7 × 7.6 µm ; Qe = 7.1
Un Crepidotus ya un poco pasadete, con esporas esféricas y minuciosamente verrucosas, el Crepidotus cesatii.
Las hifas de la suprapellis:
Los queilocistidios:
Los basidios:
Y las esporas libres:
Un muy diminuto basidiomiceto blanco sobre una hoja de haya, la Flagelloscypha minutisima:
Los basidiomas a 40 aumentos:
Un apilado de imágenes a 100 aumentos:
Los pelos externos y en la base de estos los basidios:
En este estudio no pude conseguir esporas.
Un Polyporal que oscurece sensiblemente a tonos marrones con el roce o la manipulación, un Ischnoderma, si debo ser honesto no encuentro diferencias entre este y el Ischnoderma benzoinum, si lo he separado del anterior ha sido solo por el sustrato, sobre un tronco de haya el Ischnoderma resinosum, al Ischnoderma benzoinum Ryvarden lo sitúa solo sobre coníferas, y al Ischnoderma resinosum sobre Fagus, aunque el mismo Ryvarden admite no encontrar diferencias entre ambos:
Superficie poroide a 20 aumentos:
Las hifas subiculares:
Las hifas subiculares en reactivo de Melzer:
Los basidios:
Unos basidios en reactivo de Melzer, tetraspóricos:
Muy pocas esporas conseguidas, añado una imagen de una espora ampliada con sus medidas:
Seguimos.........................................................
Adjuntos:
Última Edición: 1 año 3 meses antes por Josep Torres. Razón: Una falta de ortografía
Por favor, Identificarse para unirse a la conversación.
- Josep Torres
-
 Autor del tema
Autor del tema
- Ausente
- Moderador
-

Menos
Más
- Mensajes: 8746
- Gracias recibidas: 8379
1 año 3 meses antes #110390
por Josep Torres
Respuesta de Josep Torres sobre el tema Una docena del pasado 1 de diciembre. Microscopía.
Un Lyophyllum propio de coníferas, bajo Pinus sylvestris, el Lyophyllum semitale:
Las hifas de la suprapellis en agua:
La arista laminar en solución de amoníaco:
Los basidios en Rojo Congo:
Y las esporas en agua:
Estas esporas obtenidas por esporulación natural y en agua con unas medidas de:
(6.8) 7 - 7.9 (8.5) × (3.6) 3.9 - 4.2 (4.3) µm
Q = 1.7 - 2 (2.1) ; N = 20
Me = 7.5 × 4 µm ; Qe = 1.9
Sobre madera de haya otro Corticial, este de aspecto céreo, el Radulomyces confluens:
Superficie del basidioma a 20 aumentos:
Borde de crecimiento a 20 aumentos:
Himenio en solución de Rojo Congo:
Himenio en reactivo de Melzer:
Himenio en solución de KOH:
Los basidios en KOH, con unas medidas de (34.6) 42.4 - 45.7 (48.7) × (5.8) 6.7 - 7.9 (8.6) µm.:
Y las esporas en agua:
Estas esporas obtenidas por esporulación natural con unas medidas de:
(7.4) 7.6 - 9.1 (10.4) × (5.9) 6.2 - 7.4 (8.5) µm
Q = (1.1) 1.2 - 1.3 (1.4) ; N = 33
Me = 8.4 × 6.8 µm ; Qe = 1.2
Y ya sin microscopía:
Todo un clásico de hayedo la Megacollybia platiphylla:
También propio de hayedos, la Postia subcaesia, actualmente Cyanosporus subcaesius:
No lejos del anterior una Helvella, por su aspecto probablemente Helvella lacunosa.
Y ya de regreso sobre un tocón en la cuneta, tenemos la Blerkandera adusta:
Saludos.
Las hifas de la suprapellis en agua:
La arista laminar en solución de amoníaco:
Los basidios en Rojo Congo:
Y las esporas en agua:
Estas esporas obtenidas por esporulación natural y en agua con unas medidas de:
(6.8) 7 - 7.9 (8.5) × (3.6) 3.9 - 4.2 (4.3) µm
Q = 1.7 - 2 (2.1) ; N = 20
Me = 7.5 × 4 µm ; Qe = 1.9
Sobre madera de haya otro Corticial, este de aspecto céreo, el Radulomyces confluens:
Superficie del basidioma a 20 aumentos:
Borde de crecimiento a 20 aumentos:
Himenio en solución de Rojo Congo:
Himenio en reactivo de Melzer:
Himenio en solución de KOH:
Los basidios en KOH, con unas medidas de (34.6) 42.4 - 45.7 (48.7) × (5.8) 6.7 - 7.9 (8.6) µm.:
Y las esporas en agua:
Estas esporas obtenidas por esporulación natural con unas medidas de:
(7.4) 7.6 - 9.1 (10.4) × (5.9) 6.2 - 7.4 (8.5) µm
Q = (1.1) 1.2 - 1.3 (1.4) ; N = 33
Me = 8.4 × 6.8 µm ; Qe = 1.2
Y ya sin microscopía:
Todo un clásico de hayedo la Megacollybia platiphylla:
También propio de hayedos, la Postia subcaesia, actualmente Cyanosporus subcaesius:
No lejos del anterior una Helvella, por su aspecto probablemente Helvella lacunosa.
Y ya de regreso sobre un tocón en la cuneta, tenemos la Blerkandera adusta:
Saludos.
Adjuntos:
El siguiente usuario dijo gracias: Juan Andrés Román
Por favor, Identificarse para unirse a la conversación.
- Foro
- Foros sobre Micología de fungipedia
- Microscopía
- Una docena del pasado 1 de diciembre. Microscopía.
Tiempo de carga de la página: 0.687 segundos

Foro de micología